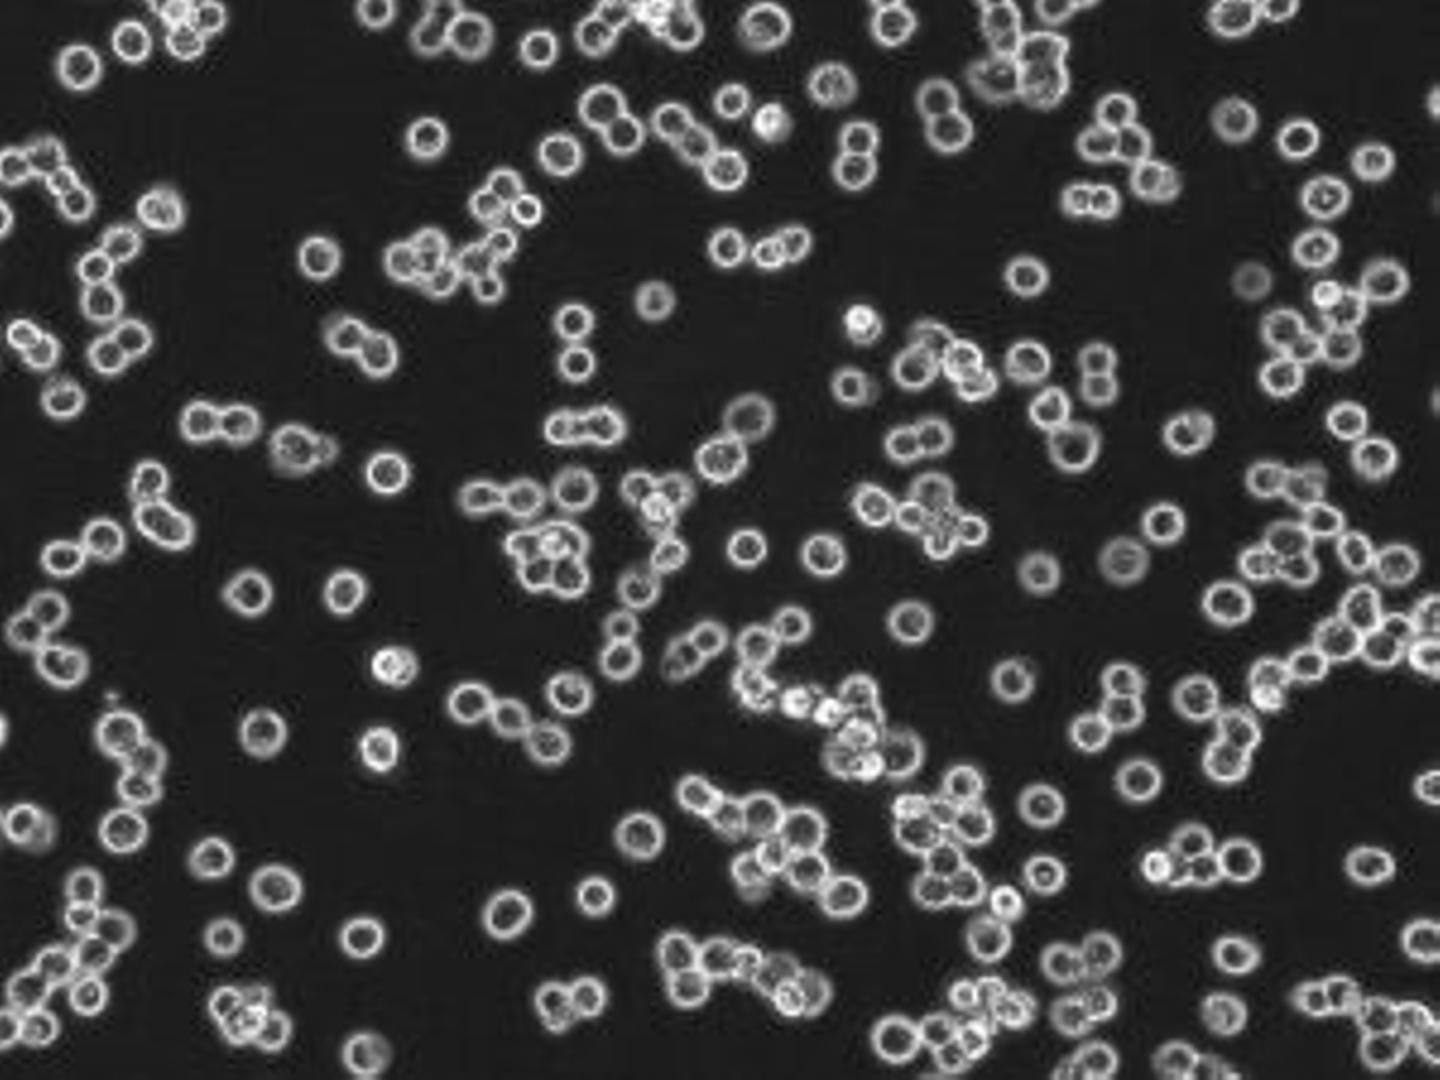

生き物たちの力を借りて豊かな未来をつくるバイオベンチャー企業群、ちとせグループ。このシリーズでは、企業という有機体を構成するひとつひとつの細胞である「ひと」にフォーカスを当て、ちとせの全体像を描いていきます。
山本 安里沙(やまもとありさ)Tech & Biz Development Div. 所属/2020年10月入社東京農業大学大学院 農学研究科 バイオサイエンス専攻ちとせグループ Tech & Biz Development Div. 細胞チーム所属。花と蜂を愛する少女が自然界に生息する菌に魅了され科学者を志す。卒業後は製薬会社でビジネスとしての研究開発経験を積み、ちとせでは細胞領域に挑戦。入社4年目の現在では細胞チームに欠くことのできない主要メンバーに。筆者の第一印象は、羽海野チカの「ハチミツとクローバー」からそのまま出てきたみたいな人。
1日の流れ
8:00 AM 起床、身支度、メールチェック、移動
9:30 AM 業務開始
10:30 AM 実験計画・準備・細胞培養・優先度の高い案件の返信
1:00 PM 会議、顧客対応
2:00 PM 医薬品製造用ヒトホスト細胞の開発実験等
6:30 PM データまとめ、メールチェック、返信
7:30 PM 業務終了
12:00 AM 就寝
————まずは、ちとせでの業務について教えてください。
まず、私が所属するちとせ研究所の細胞チームにはバイオ医薬品事業に関する二つの柱があります。一つは抗体医薬品事業で、CLDサービス*1というサービスを提供しています。ちとせが開発したCHO-MK細胞*2を「小さなお薬工場」として、製薬会社のお客様が作りたい「お薬のもと」をたくさん作るような細胞をオーダーメイドしてお渡しするサービスです。その生産性を更に上げる細胞を作ることを育種開発といいますが、「お薬のもと」をたくさん作れる細胞や、生命力が強い細胞など個性は様々で、その中から一番いいものを選び、お客様のためにカスタマイズした細胞を作ってあげるというのが私たちの仕事のひとつです。
私は抗体医薬品事業のサポートもしていますが、主にはもう一つの新しい柱である遺伝子治療事業での細胞開発を担当しています。遺伝子治療とは、遺伝子が壊れてしまっていたり、足りていない患者さんに「ウイルスベクター」と呼ばれる「お薬の運び屋」を利用して必要な遺伝子を体内へお届けする治療法です。まだ詳しくは話せないことも多いのですが、ちとせの育種技術を用いて新たに開発されたヒト由来細胞を用いて、難病治療などに使われる「お薬のもと」をたくさん作るようなスーパー細胞を今まさに絶賛開発中!という夢のある部分に携わらせていただいています。まだこの分野は発展途上で治療薬の大量生産には至っておらず、お薬の値段も高価なものは数億円と大変高額となる要因となっています。この生産効率の改善やコスト削減に繋がる細胞開発も私たちの仕事のひとつです。この研究開発を進めることで、将来的にはもっと手が届きやすい治療法にしていきたいです!
*1 Cell Line Development (バイオ医薬品製造用の発現細胞株構築受託サービス)
*2 バイオ医薬品製造用の細胞株。ちとせ研究が開発したCHO-MK細胞は従来の CHO宿主細胞株と比較して著しく高い生産性を有する。
————安里沙さんは、どんな学生だったんですか?
小さい頃からお花など綺麗なものが好きで、実は高校生になるまでずっと画家になりたいと思っていました。高校受験で志望校進学が叶わなかったことをきっかけに将来の夢を考え直していたころ、高校の生物の先生が「光る花」や「青いバラ」について教えてくれました。昔から「美しいものを作りたい」という気持ちが強くあったので、その時期から「科学的なクリエイティブ」の領域に強く興味を持つようになりました。

ちとせをイメージし今回のために描いてくれたイラスト。「千年」の象徴である鶴が、植物を手にした和装の少女に寄り添う(なんとなく本人に似ている!と筆者は思う)。
————画家の夢から科学者に、大きな転換でしたね!
そういった原体験をきっかけに、大学では花の研究ができる研究室に入り、花と菌の関係について学びました。良い菌がたくさんいたら綺麗な花を咲かせるかもしれないし、すぐに咲く花ができるかもしれない。そうして調べていくうちに、花に菌をもたらすミツバチなどの存在が重要だと知りました。なので、学生のころは虫取り網をもって全国を駆け回っていました。花は虫に蜜を与え、虫は花に菌を与える、そこにも相利共生があるのだと感動しました。ちなみに花の中にはビフィズス菌と乳酸菌がとても多いものもあるんですよ。
(花と蜂を探し求め全国を駆け回る学生時代)
————えー!?子供のころってツツジの蜜を吸うじゃないですか、あれってそういう菌を体に入れていたんですかね?
蜜を吸っているということは間違いなくビフィズス菌や乳酸菌を取り入れてますね!そういう健康法があってもおかしくない・・・(笑)ともあれ、そんな大学時代を過ごし、卒業後は菌を薬の元として製造する製薬会社に入りました。
————どういう経緯でちとせを知ったのですか?
製薬会社だと生物系の学会や講演を聞く機会が多くあるんです。そこでちとせの名前をよく見かけており、会社の中でもちとせが話題になることが多くありました。評判は良かったですよ!社内でも「転職しちゃおっか」など冗談半分で話している人もいました。
————で、本当に転職しちゃった訳ですね!
そうですね(笑)前職は長い歴史を持つ製薬会社だったので、しきたりや慣習に忠実に、というような社風がありました。また幅広い業務にみなが日々追われる中で、仕方のないことですが「この仕事は私でなく、誰でもいいのかな」と感じてしまう場面もあり、自分だからこそ任される仕事に挑戦してみたいと思っていました。
————確かに仕事の任され方や社風は様々ですよね。では、ちとせの中で気に入っている社風は何ですか?
「生き物の力を借りる」というスタンスは結構大事だと思っています。理系大学を卒業したあとで、アカデミアに残らず会社勤めをするということは、少なくとも皆さん自分の研究や実績を社会に実装したいという想いがあるのだと思います。そんな想いでいるのに、生き物を道具や単なる数字として扱うことに抵抗があるのです。ちとせにいると、たとえ細胞や菌という小さなものでもリスペクトが感じられます。生き物だから自分の思い通りに強制できるものではないので、彼らが最大限活躍できるようにマネージするというのがとても好きな社風です。
————相手がたとえ細胞でもリスペクトを感じられる訳ですね。ところで返事をしない生き物(細胞)が相手だと物足りなく感じないんですか?
確かに返事や意思表示をしてくれたらいいですね~。ご飯もう少しくださいとか、そろそろベッドを変えたいですとか。そういうAIが発達してもいいかもしれませんね。たまごっちみたいに通知が鳴ったりして(笑)それでも毎日向き合って世話をしていると愛着が湧いて来て、自然と「あの子、この子」とか「〇〇ちゃん、今日は調子よさそう」といった言い方になってくるのです。
実は採用時の選考からも相手へのリスペクトの感覚はなんとなく感じていました。選考過程のひとつが、研究や仕事内容をプレゼンするという内容だったのですが、これまでやって来たことを認めて、尊重してくれる雰囲気を感じましたし、プレゼンのあとの質疑応答でも、生き物に対するちとせの感性を感じ取ることができました。
————なるほど。面接ではどんなことを聞かれたんですか?
細胞チームとの面接では、私のプレゼン内容を理解した上で「〇〇が大変だったね」「〇〇はすごいね」など、研究内容に寄り添う言葉を掛けてくださいました。一方で、藤田さんとの最終面接では、ビジネスについてどう考えているかを聞かれました。研究職出身だと、「学問としての研究」と「ビジネスとしての研究」をきちんと切り離して考えられているか確認されると思います。また当時はコロナが始まったばかりで、慣れないZOOMで面接をしてもらったのですが、シンガポールから繋いでる藤田さんの背景がバーチャルなのか実物なのか分からないほどやけに華やかで・・・ともかくド派手な背景のおかげで(?)こちらもノリノリで話せたことを覚えています(笑)
————それは・・・笑っちゃいますね。では、いざちとせに入社して、やりがいを感じたことは何ですか?
入社してすぐに任せていただいた、羊膜から細胞を採取し、培養する仕事です。細胞チームではハムスターの他に、ヒト由来の細胞も取り扱っているのですが、それはどこからいただくかというと、妊婦さんからなんです。提携している病院の妊婦さんにインフォームドコンセントに基づいた承諾を得て、お産を終えた後の大切な胎盤の一部、羊膜から細胞を採取する作業なのですが、ついさっきまで胎児を守っていた羊膜を扱えることなんて、とても神秘的ですし、そうそうできることではありません。こんな経験を入社してすぐにさせてもらえたのはとても貴重な経験だったと思います。
————逆に大変だと感じるのはどんな時ですか?
表に出ない地味な作業が多いことですかね。実験って「細かいことをやっていそう」と思われるかもしれませんが、おそらく想像以上に本当に細かな作業が多いんです。いつ、どんなロットで、何をしたかなど、些細な作業工程も全て記録しておかなければいけない。そうでないと条件が変わってしまうので・・・

————そんな時に意識することはありますか?
基本的にはやるしかないからやっているのですが、なにより意識しているのは、無駄なことはひとつもないと思うことかもしれません。実験していて失敗や結果が出ないことが重なったとしても、「これだと失敗する」という条件が明らかになったわけです。また培養でも毎日同じような作業を繰り返すのですが、日々向き合っていると細胞の状態がより鮮明に分かるようになってきます。「今日はこのあといじっても元気にしてくれそう」、「今日は少し落ち込みそう」など・・・
————そう言い切れるのはとてもかっこいい!そして親が子の様子を見るときみたいですね。
結局は生き物なのです。ちゃんと愛着が湧くようになります。
(ヒト由来の浮遊細胞)
————チームメンバーとはどのような雰囲気ですか?
コロナが明けてから、割と頻繁にチームメンバーで食事に行くようにしています。古い考えかもしれませんが、職場だと話さないようなカジュアルなことも、場所が変わるだけでいい話題になることもあるので。こういう場を設けると仕事の場面でも空気がよくなるのを感じますね!
あとは上下に関わらず、誰でも話しかけやすい雰囲気なのはありがたいことだと思っています。ちとせでは社長も直属の上司も「〇〇さん」と呼び、肩書きで呼ばないのは特徴的ですし、知識を持っている人にアクセスしやすいのも助かっています。私自身もいつも同じテンションでいて、話しかけられやすい雰囲気を作るよう心掛けています。
————なるほど。では安里沙さんが思うちとせらしさって何だと思いますか?
一言で表すのは難しいのですが、「個の塊の調和」でしょうか。個性的な人が多いので1人1人を見たら尖っていると言えるかもしれませんが、よく分からないけどなんだか調和している状態・・・
人それぞれ得意な部分は違うと思うんです。数をこなすのが得意な人、粘り強く進める人、細かな手仕事が得意な人、精密な仕事をする人、資料をまとめるのが上手な人・・・全てをまんべんなくできることはもちろん大切ですが、仕事の工程によって得意不得意の濃淡はあるはずです。いわゆる大企業では、従業員はコマになるイメージで、1人1人は尖らずに丸くなった方がよしとされる文化があると思いますが、ちとせではひとりひとりが尖っていてもいい感じに調和しているように思います。
————確かに!この「ちとせのひと」シリーズの趣旨である「企業という有機体を構成するひとつひとつの細胞である『ひと』…」がまさにそうですね。脳細胞も爪の細胞もそれぞれ全く違うけど、ひとつの有機体を作っている。あとはちとせを「檻のない動物園」と表現した人も、いたようないなかったような・・・(笑)では最後に、応募を考えている人にメッセージをお願いします!
ちとせって何の会社?って思うくらい、多岐にわたる事業をそれぞれの方自身が主人公となり取り組んでいます。他のチームの様子や雰囲気も見えやすいので、今何がやりたいのかもわからないよって方も、飛び込んでみたら案外見つかっちゃうかもしれません。
自分で自分の価値を作り上げること、目的をもって挑戦することが好きな人は、ちとせは本当に合う会社かと思います。まだ誰もやったことのない未知な世界へ、恐れず飛び込んでやってみなさいという場面がちとせにはたくさんあるのですが、そんなドキドキをワクワクに変えて仕事がしたい方、ぜひ選考を受けてみてください。きっと、ちょっと尖った個性的な社員たちが、あなたを歓迎して出迎えてくれると思いますよ!





/assets/images/13237053/original/520d820c-8f4a-4e44-9449-5ee76c6b81d2?1683680281)
/assets/images/13237053/original/520d820c-8f4a-4e44-9449-5ee76c6b81d2?1683680281)

